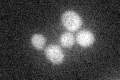
YBL075C
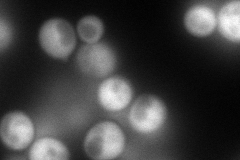
YBL075C
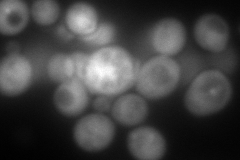
YBL075C
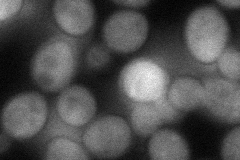
YBL075C
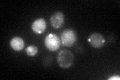
YBL075C

View description
ATPase involved in protein folding and the response to stress; plays a role in SRP-dependent cotranslational protein-membrane targeting and translocation; member of the heat shock protein 70 (HSP70) family; localized to the cytoplasm
Localization:
Intensity:
Fold change:
Significance:
-
C’ GFP library in SD
cytosol24.65 -
N' NOP1pr-GFP in SD
cytosol194.706 -
N' TEF2pr-mCherry in SD
cytosol252.101 -
N' NATIVEpr-GFP in SD

cytosol21.8779 -
N' TEF2pr-VC and Cyto-VN in SD
cytosol74.3239 -
C’ GFP library in SD+DTT

cytosol33.631.36Yes -
C’ GFP library in SD+H2O2

cytosol23.320.94No -
C’ GFP library in Starvation Media
punctateN/AN/AYes -
C’ GFP library on the background of Pup2-DaMP

cytosol -
C’ GFP library on the background of CCT mutant

cytosol21.46170.870209No
